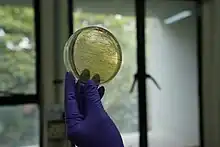

Centre de biologie cellulaire et moléculaire d'Hyderabad
Le Centre de biologie cellulaire et moléculaire (en hindi : कोशिकीय एवं आण्विक जीवविज्ञान केंद्र , IAST : Kośikīya evam āṇavik jīvavijñāna kendra; en anglais : Centre for Cellular and Molecular Biology ou CCMB) est un établissement indien de recherche fondamentale en sciences de la vie situé à Hyderabad qui opère sous l'égide du Conseil indien de la recherche scientifique et industrielle (Council of Scientific and Industrial Research). Le CCMB est un « Centre d'excellence » désigné par le Réseau mondial de biologie moléculaire et cellulaire de l'UNESCO[1],[2].
Histoire
Le CCMB est initialement créé en tant que centre semi-autonome le , à partir du département de biochimie du laboratoire de recherche régional de l'époque (actuellement l'Institut indien de technologie chimique (en), IICT, à Habsiguda, Hyderabad). Auparavant, en 1976, le conseil d'administration du CSIR (le Conseil indien de la recherche scientifique et industrielle (en), basé à New Delhi, l'organe suprême qui coordonne 44 instituts de recherche - aujourd'hui 38 - dans le pays), avait approuvé la proposition de créer un tel centre compte-tenu de l'importance de mener des recherches dans les domaines exploratoires et multidisciplinaires de la biologie moderne. De 1981 à 1982, le CCMB se voit accorder le statut de laboratoire national à part entière avec son propre comité exécutif et son propre conseil consultatif scientifique. Au vu de son développement, le centre est par la suite déménagé sur un campus spacieux.
Recherche
Les programmes de recherche en cours au CCMB se répartissent en trois catégories principales : la recherche fondamentale de haute qualité dans les domaines pionniers de la biologie moderne, la recherche en réponse aux besoins de la société, et la recherche axée sur les applications en vue de la commercialisation. Cette dernière inclut les domaines de l'évolution et du développement, la régulation des gènes chez les procaryotes et les eucaryotes, les interactions hôte-parasite, la biologie membranaire, la structure des protéines, la biologie des cellules souches, la neurobiologie, la bio-informatique, la génomique fonctionnelle, l'écologie et les écosystèmes.
Annexe I – LaCONES

Le Laboratoire pour la conservation des espèces menacées (en) est une annexe du CCMB dont le but est de conserver la faune indienne en utilisant des techniques biologiques modernes et des technologies de reproduction assistée. Il a beaucoup travaillé avec divers départements du gouvernement indien pour lutter contre la criminalité liée aux espèces sauvages. Il permet d'identifier la source de viande animale en cas de doute, les sources d'animaux de contrebande et d'étudier le stress chez les animaux sauvages via des mesures non invasives. Il a aidé la Direction de la sécurité aérospatiale à identifier la raison des impacts d'oiseaux et les a aidés dans l'ingénierie de la canopée de leurs aéroports. Il héberge la National Wildlife Genetic Resource Bank qui comprend actuellement 250 échantillons génétiques d'animaux, collectés dans des zoos à travers le pays. La National Wildlife Genetic Resource Bank peut préserver jusqu'à 17 000 échantillons. Au cours des dernières années, il a travaillé avec le Nehru Zoological Park (en) à Hyderabad pour protéger le cerf souris de l'extinction. En août 2018, il a commencé la libération progressive de ces animaux dans leurs habitats d'origine de la réserve de tigres d'Amrabad.
Annexe II – Complexe de biotechnologie médicale
Le CCMB effectue des tests de diagnostic moléculaire pour 30 troubles génétiques et des analyses médico-légales de la faune dans son complexe de biotechnologie médicale, également connu sous le nom de Innovation Hub (iHUB). Il abrite également le Centre d'incubation Atal-CCMB (AIC-CCMB)] pour soutenir les startups en sciences de la vie à un stade précoce. Cette initiative est soutenue par NITI Aayog et Atal Innovation Mission. Elle a soutenu des startups travaillant dans la découverte de médicaments, la réutilisation de médicaments, le développement de vaccins, le diagnostic, la nutrition et le développement de nanomatériaux. Elle héberge désormais un MeitY (en) Startup Hub pour incuber des startups qui se penchent sur les mégadonnées dans le secteur des sciences de la vie/de la santé.
Collaborations
Le centre collabore activement avec des biologistes en Inde et à l'étranger. La liste de collaborations présentes et passées comprend l'Institut de recherche fondamentale Tata, la Direction de la recherche sur le riz (en), l'Université d'Hyderabad (en),l'Institut de génomique et de biologie intégrative (en), le Centre national de recherche sur la viande (en).
Le centre a collaboré avec le Centre médical de l'université du Nebraska pour la recherche translationnelle sur le glaucome. En outre, le centre reçoit des financements pour des projets de collaboration spécifiques d'établissements situés en dehors de l'Inde, tels que les National Institutes of Health, la Harvard Medical School et le Massachusetts Institute of Technology aux États-Unis[3],[4], l'Imperial Cancer Research Fund et l'université de Cambridge au Royaume-Uni[5], l'India-Japan Science Council et l'université des Ryūkyū au Japon[6], le Centre national de la recherche scientifique et l'Institut Pasteur en France et la Fondation Volkswagen en Allemagne[7], [8].
Réalisations technologiques

- Développement de la technologie d'empreintes digitales ADN en Inde, ce qui fait de l'Inde le troisième pays au monde à disposer de sa propre technologie de prise d'empreintes digitales ;
- Développement de la technologie d'amorce universelle qui permet d'identifier l'espèce d'animal source à partir de n'importe quel produit animal ;
- Découverte de la mutation de la maladie cardiaque, portée par 60 millions de personnes parmi les Indiens[9] ;
- Mise au point par génie génétique de la première KO gène souris en Inde[10] ;
- Démonstration de la première insémination artificielle chez le cerf[11] ;
- Développement d'un programme systématique de dépistage et de validation des médicaments anticancéreux en Inde[12] ;
- Découverte du caractère unique de la population indienne grâce à des études génomiques ;
- Découverte de l'origine des tribus Andaman[13] ;
- Kit de diagnostic basé sur la technologie de l'ADN recombinant commercialisé pour la détection d'agents pathogènes causant des infections ophtalmiques[14] ;
- Découverte de riz à haut rendement résistant aux maladies[15] ;
- Découverte de bactéries indigènes, Indibacter alkaliphilus, utilisées pour générer des enzymes et des biomolécules dans le secteur de la biotechnologie industrielle[16] ;
- Découverte de la fonctionnalité des microsatellites (répétitions de séquences simples) parmi l'ADN non codant[17] ;
- Découverte du gène CPA1, responsable de la pancréatite chronique, en collaboration avec l'Asian Institute of Gastroenterology[18].
Pertinence sociétale du CCMB
Les scientifiques actuels et passés du CCMB ont joué un rôle important dans la fondation et la direction de nombreux instituts de recherche et d'enseignement en Inde. Cela comprend la création du Centre pour les empreintes digitales et le diagnostic ADN (en) (CDFD) à Hyderabad, après le succès de la technologie des empreintes ADN comme forme acceptée de preuve dans le système judiciaire indien. Le CCMB a résolu plusieurs affaires criminelles très médiatisées de meurtres, d'assassinats et de viols en utilisant la technologie d'empreintes génétiques. Cela inclut les cas de Rajiv Gandhi, Beant Singh, Naina Sehwal, Priyadarshini Mattoo, la femme de Swami Shraddhananda et Swami Premananda. La technologie des empreintes génétiques a également permis d'identifier les victimes de l'accident d'avion de Singapore Airlines en 2000.
Dans les années 1990, le CCMB a incubé la première entreprise de biotechnologie de l'Inde, Shantha Biotechnics Ltd, et les a aidés à développer leur vaccin recombinant contre l'hépatite B, abordable pour toute la population indienne.
Il a joué un rôle déterminant dans la lutte contre le COVID-19 en Inde. C'est l'un des centres d'analyse des échantillons de patients du Telangana. Il vise également à contribuer à la compréhension de base de la biologie du SRAS-CoV2 pour aider à développer des vaccins et des médicaments.
Prix et distinctions
En reconnaissance de sa contribution à la biologie moderne, le CCMB a été choisi comme centre d'excellence par le Réseau mondial de l'UNESCO pour la biologie moléculaire et cellulaire (MCBN), et a été désigné comme centre d'excellence du Sud pour la recherche et la formation par l'Académie des Sciences du monde TWAS. De nombreux prix internationaux et nationaux prestigieux ont été décernés au CCMB, notamment le prix CSIR Technology (quatre fois) et le prix FICCI pour des réalisations exceptionnelles en science et technologie.
Les scientifiques du CCMB sont lauréats d'un Padma Bhushan, de quatre Padma Shri, de trois prix Infosys et de 11 prix Shanti Swarup Bhatnagar.
Voir également
Notes et références
- (en) Cet article est partiellement ou en totalité issu de l’article de Wikipédia en anglais intitulé « Centre for Cellular and Molecular Biology » (voir la liste des auteurs).
- « The Hindu Business Line : CCMB develops DNA test to identify animal species », sur web.archive.org, (consulté le )
- « CCMB identifies milk gene - Times Of India », sur web.archive.org, (consulté le )
- « Harvard School of Public Health » HSPH News » New research reveals the ancestral populations of India and their relationships to modern groups », Hsph.harvard.edu, (consulté le )
- « caste system existed from 'Founder' race: CCMB-Harvard-MIT study », News.webindia123.com, (consulté le )
- « Modern man went into the world via India », Epaper.timesofindia.com, (consulté le )
- Ndhlovu, Leal, Hasenkrug et Jha, « HTLV-1 Tax Specific CD8+ T Cells Express Low Levels of Tim-3 in HTLV-1 Infection: Implications for Progression to Neurological Complications », PLOS Negl Trop Dis, vol. 5, no 4, , e1030 (PMID 21541358, PMCID 3082508, DOI 10.1371/journal.pntd.0001030)
- « Research > Research Partners » [archive du ], Ccmb.res.in (consulté le )
- « Education Plus : Opening new vistas of research in biology », The Hindu, Chennai, India, (lire en ligne, consulté le )
- The worst luck in the world? - Wellcome Trust Sanger Institute
- « Scientists complete work on gene knockout technology », The Hindu, Chennai, India, (lire en ligne, consulté le )
- CCMB implements artificial insemination in deer - India - DNA
- « CCMB scientists develop new drug assay system », The Times of India, (lire en ligne, consulté le )
- « DNA fingerprinting has come a long way, says Lalji Singh », The Hindu, Chennai, India, (lire en ligne)
- « CCMB scientists develop new method to test cancer », The Times of India, (lire en ligne, consulté le )
- « CCMB grows pest-resistant Samba Masuri rice strain », The Times of India, (lire en ligne, consulté le )
- « New found bacteria get Indian nomenclatures », The Hindu, Chennai, India, (lire en ligne)
- DNA: CCMB scientists achieve breakthrough - The New Indian Express
- Scientists from CCMB and AIG Discovered Gene Causing Chronic Pancreatitis
- Portail de l’Inde
- Portail des sciences
- Portail de la biologie